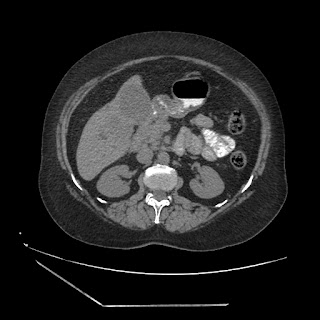

A 70 years old woman with Obstractive jaundice & palpable GB
This is a HIPAA de-identified open-online-patient-record, posted on autumn 2015 after collecting informed patient consent (form downloadable here ) by LNMCH research assistant and patient-information-communication-executive and discussion initiated by patient's primary care physician in-charge:
Conversational clinical decision support from online learning forum:
Present
complaints:
Pain in abdomen
Fever
Headache
Vertigo
Yellowish eyes
Distension &
Tenderness of abdomen
Slightly in edema in both
legs
Nausea &
vomiting
Dullness
Loss of appetite
Constipation
Yellowish urine